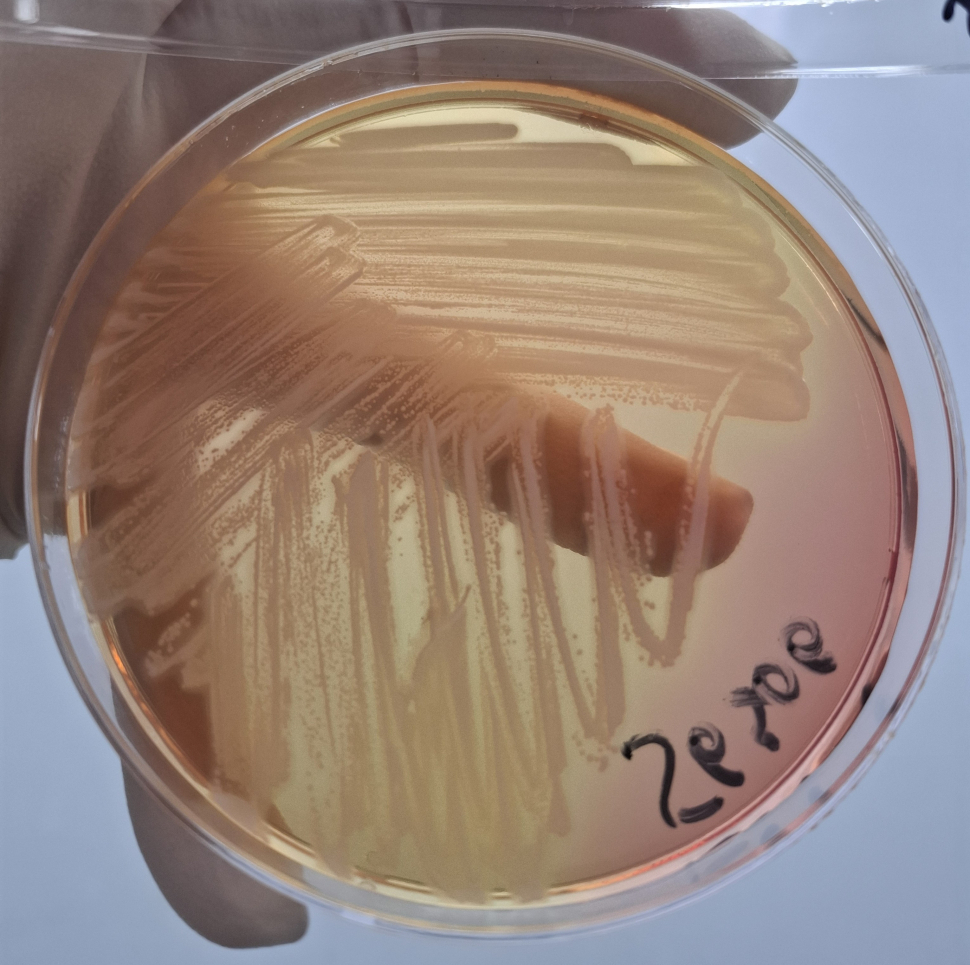

20250923_152813
Камера: Galaxy A55 5G
ISO: 50
Выдержка: 1/100
Диафрагма: F/1.9
Фокусное расстояние: 5.54
Снято: 23 сентября 2025 15:28
Альбомы: отит у собаки_14102025